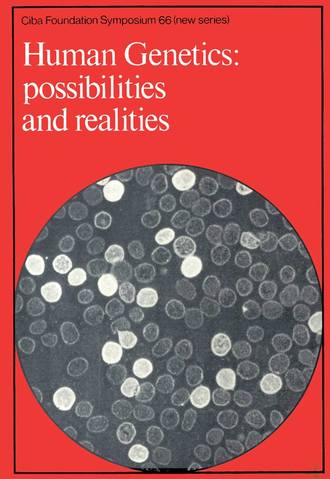
Human Genetics

Human Genetics
Автор:
Жанр:
Год написания книги: 2019
The Novartis Foundation Series is a popular collection of the proceedings from Novartis Foundation Symposia, in which groups of leading scientists from a range of topics across biology, chemistry and medicine assembled to present papers and discuss results. The Novartis Foundation, originally known as the Ciba Foundation, is well known to scientists and clinicians around the world.
На сайте электронной библиотеки Litportal вы можете скачать книгу Human Genetics в формате fb2.zip, txt, txt.zip, rtf.zip, a4.pdf, a6.pdf, mobi.prc, epub, ios.epub, fb3. У нас можно прочитать отзывы и рецензии о этом произведении.